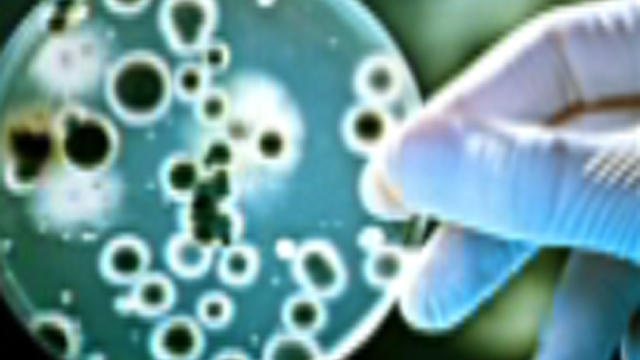

Plane slides off runway into river in Florida
Male makeup is catching more mens’ eyes
Beauty products for men are gaining traction in the U.S. on the heels of a growing male grooming and skin care market
5H ago
FDA warns that French cheese may be tainted with listeria
Product made with pasteurized cow’s milk was distributed throughout the United States
7H ago

Is this record-setting stock market setting up investors for a fall?
If you’re worried that stock prices can’t get much higher, you might want to review this list of market indicators
Apr 30

Kelly joins board of company operating shelters for migrant children
Caliburn International, which runs a massive shelter in Homestead, Florida, confirmed Friday that the former White House chief of staff has joined its board
1H ago

The rise of female gun ownership and fashionable “carrywear”
Alexo Athletica designed a pair of Lulelemon-like leggings with pockets for guns — and women gun owners took notice
Apr 26




Leave a Reply